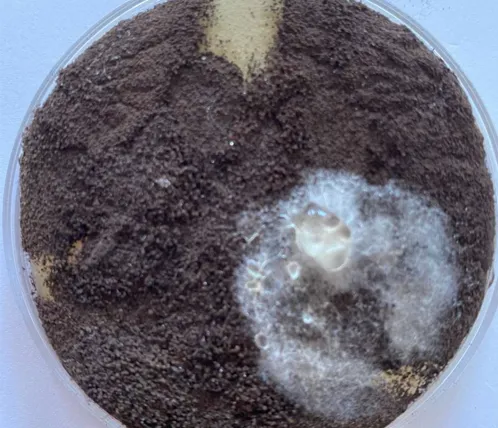

小屋裏ダクト結露が招く天井崩落|全館空調の断熱と湿度の死角
2026/02/14
小屋裏のダクト結露が招く天井崩落の危機|全館空調の死角「断熱と湿度の相関
目次
全館空調システムは、家全体の温度を一定に保つ素晴らしい技術ですが、その心臓部とも言えるダクトの多くは、普段目にすることのない「小屋裏(屋根裏)」を縦横無尽に走っています。もし、ご自宅の天井にうっすらとしたシミが現れたり、特定の部屋でカビ臭さを感じたりするなら、それは単なる表面の汚れではなく、小屋裏で深刻な「結露」が発生しているというシステムからの悲痛なサインかもしれません。夏の関東エリアにおける小屋裏は、屋根からの輻射熱によって50℃を超える過酷な高温多湿環境となります。一方で、全館空調のダクト内には15℃前後の冷たい空気が流れており、この圧倒的な温度差がダクト表面に大量の結露水を生じさせます。天井を形作る石膏ボードの裏側に音もなく溜まり続け、カビにとって最高の培養地を作り上げます。石膏ボードの主成分である紙や接着剤はカビの格好の餌となり、私たちが表面で異変に気づいた時には、裏側はすでに広範囲にわたって黒カビに浸食され、ボード自体の強度が著しく低下しているケースが少なくありません。最悪の場合、水分を含んで脆くなった天井が、ある日突然、大量のカビ胞子を撒き散らしながら崩落するという「住まいの重大事故」に繋がるリスクを秘めているのです。
関東エリア特有の「高湿度」と「住宅構造」が招く結露のメカニズム
全館空調のカビトラブルは、日本全国一律に起こるわけではありません。カビバスターズ東京が現場で目にする事例の多くは、関東エリア(東京、神奈川、埼玉、千葉、茨木、山梨、栃木、群馬)特有の気候条件と、近年のトレンドとなっている住宅設計の「ミスマッチ」から生じています。
関東の夏は「熱帯化」している|ダクトが悲鳴を上げる外気条件
近年の東京や横浜の夏は、単なる高温ではなく「極端な高湿度」が特徴です。ゲリラ豪雨の直後、強烈な日差しで熱せられた小屋裏の湿度は90%近くに達することも珍しくありません。露点温度の跳ね上がり:湿度が上がれば上がるほど、結露が始まる「露点温度」は上昇します。例えば、小屋裏の温度が35度で湿度が85%の場合、表面温度が約32度以下の物体にはすべて結露が生じます。24時間連続冷却の功罪:全館空調は「常に冷やし続ける」ことで快適さを保ちますが、これはダクトが24時間、常に「露点以下」にさらされ続けることを意味します。一度も乾燥する暇がないため、結露水は乾くことなく蓄積し続けるのです。
軒ゼロ住宅」と「片流れ屋根」の流行が招く換気不足
デザイン性を重視した「軒の出がない(軒ゼロ)」住宅や、スタイリッシュな「片流れ屋根」の住宅が関東の都市部では急増しています。それに加えて、建築基準法(斜線制限・絶対高さ・高度地区)や全体の広さ(階数の合計)を制限される 容積率などで、全館空調を導入するようなこだわりの住宅を建てる際、この「高さ制限」のせいで小屋裏(屋根裏)のスペースが極端に狭くなり、それがダクトの無理な配管や結露トラブルに繋がるケースもあり、特に2階などの直射日光があたる屋根裏は注意が必要です。本来、空気は屋根裏の湿気は軒下から入り、屋根の頂点(棟)から抜けるのが理想です。しかし、換気効率の悪い設計では、全館空調のダクト周辺に湿った熱気が停滞し、結露のリスクを爆発的に高めます。限られた小屋裏スペースに無理にダクトを通すことで、断熱材が圧迫されて薄くなったり、急な屈曲部で結露が生じやすくなったりする「施工上の死角」が生まれやすいのです。
石膏ボードが「吸水」を開始する沈黙のプロセス
1.小屋裏で発生した結露水は、ダクトを伝って滴り落ち、天井を構成する石膏ボードの「裏面」に直接降り注ぎます。
2.浸透:石膏ボードの裏紙が水分を吸収。この段階では室内の天井面には変化が見えません。
3.停滞:ボード内の石膏層が保水力を持ち、常に湿った状態が維持されます。
4.繁殖:暗所かつ栄養源(ボードの紙や糊)が豊富な裏面で、カビが爆発的に増殖を開始します。
貫通:カビの菌糸が石膏ボードの組織を突き抜け、ついに室内のクロス(壁紙)側に「シミ」や「黒ずみ」として姿を現します。
専門家からのアドバイス:早期発見のチェックリスト
カビバスターズ東京が推奨する、天井崩落を防ぐためのセルフチェックポイントです。
・吹き出し口の縁(ふち)に水滴がついている。
・天井の特定の場所が、他と比べてわずかに「たわんで」見える。
・エアコンをつけているのに、家の中が「土臭い」「酸っぱい」臭いがする。
・エアコンの送風口から近い天井や壁が黒ずんている。
・スポットライトの周りが黒ずんでいる。
・2階の収納スペース(枕棚など)の奥にカビが発生している。
これらの一つでも当てはまる場合、小屋裏ではすでに「ダクト結露による石膏ボードの浸食」が始まっている可能性が高いと言えます。
石膏ボードの深層汚染と健康リスク|真菌学的視点からの警告
全館空調のダクト結露によって湿った天井裏は、単に「汚れている」だけではありません。そこは、特定の有害なカビ(真菌)が爆発的に増殖する「バイオハザード空間」と化しています。
なぜ石膏ボードは「最悪の汚染源」になるのか
石膏ボードは、現代建築には欠かせない優れた建材ですが、一度水分を含むとカビにとっては繁殖場へと変貌します。
多孔質構造による菌糸の侵入
石膏は微細な穴が無数に開いた多孔質の物質です。カビの根にあたる「菌糸」はこの微細な穴に深く入り込み、表面を拭いただけでは決して除去できない「深層汚染」を引き起こします。
セルロースという栄養源
石膏を包む表面の厚紙はセルロースでできています。これは多くのカビにとって主食のようなものです。さらに、ボードを貼り合わせる際に使用されるデンプン系の接着剤が、増殖をさらに加速させます。
防カビ剤の限界
一般的な石膏ボードにも一定の防カビ性能がある場合がありますが、小屋裏の結露のように「持続的な水分供給」がある環境では、防カビ成分が流失・分解され、効果を失ってしまいます。
天井裏で増殖する「三大有害カビ」
全館空調のトラブル現場において、カビバスターズ東京が頻繁に検出する代表的な菌種を挙げます。
アスペルギルス(麹菌属)
非常に乾燥に強く、かつ湿った環境でも猛威を振るいます。胞子が非常に小さいため、全館空調の風に乗って肺の奥深くまで入り込みやすく、日和見感染症の原因となります。
ペンシリウム(アオカビ属)
湿った建材で真っ先に繁殖する菌種です。マイコトキシン(カビ毒)を産生するものもあり、吸い込み続けることでアレルギー性疾患を引き起こします。
クラドスポリウム(クロカビ属)
結露がある場所に必ずと言っていいほど現れる黒いカビです。喘息の最大の原因物質(アレルゲン)として知られており、空中浮遊菌として最も多く検出されます。
全館空調が引き起こす「夏型過敏性肺炎」の恐怖
全館空調住宅にお住まいの方に、特に知っておいていただきたいのが「夏型過敏性肺炎」です。これは、カビの胞子を繰り返し吸い込むことで肺が過剰な免疫反応を起こす病気です。
症状の罠
咳、微熱、だるさなど「風邪」にそっくりな症状が出ます。
全館空調との相性
冷房を使用する夏場に症状が悪化し、外出したり冬になったりすると治まるのが特徴です。全館空調の場合、家中どこにいても胞子を吸い込み続けるため、逃げ場がないのがこの問題の恐ろしさです。
慢性化のリスク
放置すると肺が繊維化し、呼吸機能が取り戻せなくなる恐れもあります。「家の中にいると、なぜか咳が出る」というサインを見逃してはいけません。
健康を守るための「空気の検診」
カビバスターズ東京からの提言:健康を守るための「空気の検診」
天井にシミが現れたり、部屋にカビ臭が漂い始めたりしたとき、それは単なる表面的な汚れではなく、住まいの深部で「異常事態」が起きているサインです。全館空調のダクト結露によって天井石膏ボードの裏側が侵食されている場合、もはや一般的なハウスクリーニングで対応できる領域を大きく超えています。石膏ボードはその構造上、一度内部まで菌糸が入り込むと、表面を拭き取っただけでは決して死滅しません。むしろ、空調の風に乗って目に見えない胞子が家中を漂い続け、ご家族の健康を日常的に脅かす「健康リスクの源泉」と化してしまいます。カビバスターズ東京は、単なる清掃業者ではありません。私たちは科学的知見に基づき、目に見えない胞子の浮遊状況の測定や、天井裏に隠れた汚染範囲の精密な特定を行います。建物の構造から菌の特性までを熟知しているからこそ、その場しのぎではない「根本的な処置」が可能となります。家族が安心して深呼吸できる、本来の健やかな住環境を取り戻すために。まずは現状を科学的に正しく知ることが、解決への唯一にして最大の第一歩です。
家族の健康と資産を守るために
全館空調のカビ問題は、建物の構造と空調システム、そして真菌学という複数の専門知識が交差する非常に複雑な領域です。一度石膏ボードの深層まで浸食したカビは、表面的なクリーニングで解決することはありません。
カビバスターズ東京に相談するメリット
科学的根拠に基づく調査:目視だけでなく、菌検査や環境測定を通じて「見えないリスク」を可視化します。
根本解決の提案:カビを取り除くだけでなく、なぜ結露が起きたのかという原因を特定し、再発させないためのアドバイスを行います。
関東エリアに特化した知見:1都7県(東京都・神奈川県・千葉県・埼玉県・茨城県・栃木県・群馬県)の多様な住宅構造と気候特性を熟知しているため、その土地に最適な対策が可能です。
【ご相談から解決までの流れ】
まずは、カビバスターズ東京 公式ホームページの専用フォーム、またはお電話にてお問い合わせください。
STEP 1:ヒアリング(現在の症状や築年数、平面図、立面図、空調メーカーの確認)
STEP 2:現地調査・精密診断(小屋裏の状態を徹底確認)
STEP 3:診断報告・プラン提示(状況に合わせた最適な対策をご提案)
全館空調は、正しく機能してこそ最高の快適性を提供してくれます。天井のシミや原因不明の体調不良に悩まされる前に、空気のプロである私たちにぜひご相談ください。住まいの「健康」を取り戻すパートナーとして、全力でサポートいたします。
■カビ検査・カビ調査・カビ取り・除菌などカビの事なら何でもお任せください■
-------カビ対策専門のカビバスターズ東京---------
対応エリア:東京・神奈川・千葉・埼玉・栃木・群馬・山梨・静岡・長野
お客様専用フリーダイヤル:0120-767-899
TEL:050-5527-9895 FAX:050-3131-0218
株式会社ワールド|カビバスターズ東京
【本社】〒152-0004 東京都目黒区鷹番1丁目1-5 フラットフォー本社ビル4F
【世田谷営業所】〒157-0067 東京都世田谷区喜多見2丁目5-1 PenthouseTB2F